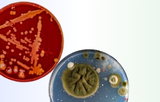

American Radiolabeled Chemicals
|
|
Website:http://www.arcincusa.com |
|
American Radiolabeled Chemicals, Inc. (ARC). Since its inception in 1983, ARC has established itself as one of the leading suppliers of high-quality radiolabeled and unlabeled chemicals in the world. Their 2024 catalog contains more than 4,500 radiolabeled and unlabeled chemicals for life science research. Here are some key points about ARC:
Website: www.arcincusa.com
|
||